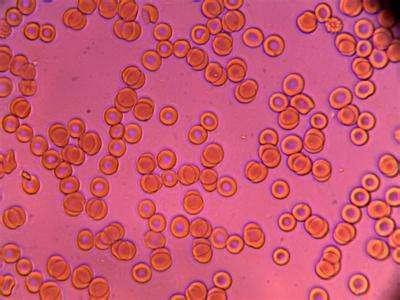

-
UID: 1627269 
-
- 注册时间2012-09-03
- 最后登录2025-12-18
- 在线时间36802小时
-
- 发帖296853
- 搜Ta的帖子
- 精华2
- 金币34288
- 道行40006
- 原创108
- 奖券147
- 斑龄0
- 道券30
- 获奖0
-
访问TA的空间加好友用道具
UID: 1627269 
- 发帖
- 296853
- 金币
- 34288
- 道行
- 40006
- 原创
- 108
- 奖券
- 147
- 斑龄
- 0
- 道券
- 30
- 获奖
- 0
- 座驾
-
- 设备
-
- 摄影级
-
在线时间: 36802(小时)
注册时间: 2012-09-03
最后登录: 2025-12-18
|
—
本帖被 妞妞乐乐 执行加亮操作(2020-12-13)
—
甘油三酯是血液中的一种脂肪类物质,大部分是来自饮食。甘油三酯的主要作用是为人体提供和储存能量。虽然甘油三酯对人体有着重要作用,但也不能超量。血液中甘油三酯高的危害虽然隐匿难以觉察,但任其发展下去,甘油三酯高的后果却很严重。
甘油三酯危害一:诱发冠心病
大量事实表明,甘油三酯高已成为动脉粥样硬化、冠心病及其他心血管疾病的重要危险因素之一。甘油三酯高已成为冠心病相关标志之一。

甘油三酯危害二:导致血液粘稠
甘油三酯高的危害最直接体现在动脉粥样硬化上。甘油三酯高的后果是容易造成“血稠”,即血液中脂质含量过高导致的血液粘稠,在血管壁上沉积,渐渐形成小斑块,即我们平时说的动脉粥样硬化。而血管壁上的这些块状沉积会逐渐扩大面积和厚度,使血管内径变小、血流变慢,血流变慢又加速了堵塞血管的进程,严重时血流甚至被中断。
甘油三酯危害三:诱发肾病、失明、中风等
除了血流中断,阻塞物脱落还能造成血栓;甘油三酯高的后果无论发生在哪个部位,对人体损伤都很严重。如果在心脏,可引起冠心病、心梗;在大脑,可发生脑卒中、中风;发生在眼底,会导致视力下降、失明;如在肾脏,可引起肾衰;发生在下肢,则出现肢体血流不畅导致坏死。

甘油三酯危害四:诱发多种结石
甘油三酯高的危害还包括引发高血压、胆结石、胰腺炎;还能够加重肝炎、致使男性性功能障碍、导致老年痴呆等。研究表明,甘油三酯高的后果还包括一点,它可能导致癌症的发生。
|